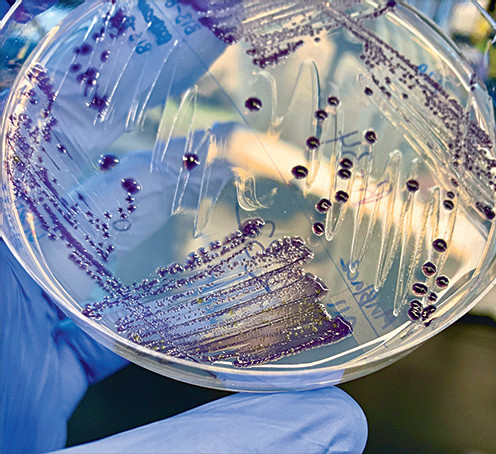

Технопарад

Внеземная жизнь
Скафандры не самая гигиеничная вещь: космонавты в них обильно потеют, а ни почистить, ни постирать такую «одежду» невозможно. На будущей лунной базе эта проблема станет особенно острой, ведь там каждый скафандр придется делить между как минимум несколькими людьми – а возможно, и несколькими десятками.

Для создания скафандров с бактерицидными свойствами Европейское космическое агентство (ESA) реализует проект по разработке новых тканей PExTеx. Такие материалы должны защитить космонавтов не только от жестоких условий безвоздушного пространства, но и от микробов, которые могут размножаться во внутренней оболочке. Последней задачей занимается австрийский институт OeWF, создавший антибактериальное покрытие BACTeRMA. В его основе – вещества, которые производят некоторые микробы для борьбы с конкурентами, аналоги антибиотиков, такие как виолацеин и продигозин, которыми пропитывается ткань. В соответствии с техзаданием ESA материалы должны выдерживать использование в течение минимум 2500 часов. По этому сейчас они проходят тесты в немецком институте текстиля DITF, где для них создают имитацию космического пространства, включая глубокий вакуум, экстремальные перепады температур и радиацию. Если все пройдет по плану, из новых тканей сделают прототипы скафандров, которые в 2024 году пройдут испытания в Армении в рамках европейского эксперимента – симуляции полета на Марс.
Экзоскелеты: Железные дорожники

Куда бы ни вырулил прогресс, а работа железнодорожников остается физически изнурительной и тяжелой. Для облегчения их труда инженеры Итальянского института технологий (IIT) создали экзоскелет StreamEXO, специально адаптированный под задачи, связанные с подъемом и переноской грузов. Как показали полевые испытания, которые проходили при строительстве нового участка железнодорожного полотна под Миланом, обеспечивая дополнительную поддержку мышцам спины, экзоскелет снижает утомление своего носителя на 30%, а риск производственных травм – на 50%. StreamEXO весит всего 7 кг, включая батарею, которая обеспечивает до 6 ч. непрерывной работы. При этом одну и ту же модель можно настроить для людей разного роста и веса.
Биология: Радужная анатомия

Яркими цветами светится на картинке нервная система лабораторной мыши. Конкретный оттенок соответствует местоположению окрашенных клеток: желтые и розовые находятся дальше от камеры, синие – ближе. Такая визуализация стала возможной благодаря новому методу wildDISCO, созданному биологами из Мюнхенского исследовательского центра им. Гельмгольца. Для этого из тела мертвого животного удалили холестерин, а затем ввели антитела, несущие флуоресцентные красители. Антитела связываются с клетками определенного типа, после чего полученный снимок проходит компьютерную обработку. Ученые надеются, что wildDISCO позволит лучше понять детали многих важных биологических процессов, от работы нервной системы и до развития рака.
Строительство: Дом-гриб

«Грибобетоном» (mycocrete) назвали новый строительный материал разработчики из британского Университета Ньюкасла. Для его получения действительно используются грибные споры, которые перемешиваются с измельченной бумагой, глицерином, водой и ксантановой камедью – полисахаридом, который сгущает все в пасту. Эту смесь вносят в пористую текстильную структуру и помещают в темное, теплое и влажное место, позволяя спорам прорасти. Затем из них вытягиваются нитевидные гифы, фиксируя текстиль в нужной форме; далее ее остается лишь высушить в определенный момент, чтобы не дать грибам созреть. Ученые продемонстрировали технологию, собрав небольшой «грибобетонный» вигвам, который можно видеть на фотографии.
Телеприсутствие: Робот-пес, он же кот

Роботы остаются недостаточно умными, а люди – недостаточно прочными для многих задач, связанных с работой в космосе. Поэтому одним из перспективных направлений развития космонавтики считается создание систем, дистанционно управляемых с земли или борта орбитальной станции. Такие эксперименты прошли недавно в Баварии, где несколько роботов действовали под контролем астронавта Андреаса Могенсена, который командовал ими, оставаясь на МКС.

